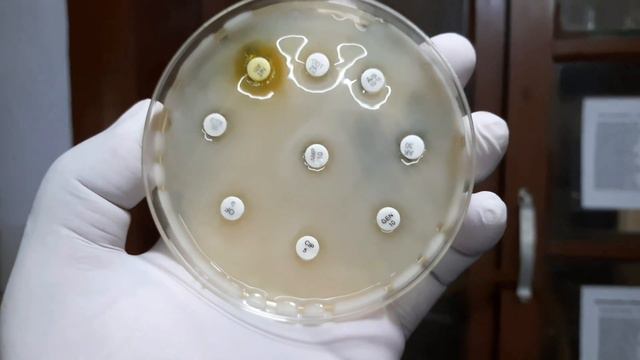
Klebsiella colony characteristics, Gram Stain,Biochemical Tests, Antimicrobial sensitivity testing смотреть онлайн

Автор: Забота о растениях: секреты и рецепты Страница 3

My Godzilla Syngonium / What's in the Pot? / The Reason Why I didnt Repot? #plantlover #syngoniums

Кольцо "Морская звезда на синем цветке" v2
Klebsiella colony characteristics, Gram Stain,Biochemical Tests, Antimicrobial sensitivity testing

Nagami Kumquat!!! Some of the best citrus in the southeast!

Прогулки во времени - «Утро с Вами» 18.09.2017

Крым в сердце моем 10 11 22 старший состав

Немного зелени...

С Праздником весны!🌺🌺🌺💖

Plum Perfect|梅子色完美|颜色漂亮|健康多花 |Nature Sounds

Питер - Подстаканники

Выставка строительной техники 2016-4

Строительство. Архитектура. Недвижимость 2018 - Открытие

Quick Spring Planter With Tete a Tete Daffodils & Hyacinth

Театр " Русская песня " . Россия , Москва . Ноябрь 2017 год .

The Importance of Writing in Music - Rogue Writers Podcast #13

Decisions

ШОППИНГ ПО😃 ТОРГОВОМУ ЦЕНТРУ 🏢

Stability Ball Core Workout for beginners - Swiss ball core exercises

Ботанический сад Беларуси впервые показал закрытый коллекционный фонд

Vacation Vlog #1 // Mui Né, Vietnam

mostrando as minhas rosas do deserto amarela, vermelha, e rosa ❤🤣❤😂💖❤

От романса до джаза.

Osmo Primer - The ideal first coat before installation

TRANSPLANTING SQUASH🌱 A TOUR, WINTER SOWN GREENS🌿, MY ALLOTMENT & CONTEST UPDATE |ZONE 5B GARDEN
За каждым успешным каналом стоит личность, идея и сотни часов кропотливого труда. Если вы здесь, значит, автор «Забота о растениях: секреты и рецепты» уже сумел зацепить ваше внимание своим уникальным стилем или подачей. А мы на RUVIDEO позаботились о том, чтобы вы могли изучить весь архив его работ в максимально комфортных условиях — без лишней суеты и преград.
Почему за работами канала «Забота о растениях: секреты и рецепты» так интересно наблюдать? Всё просто: это честный контент, который находит отклик в сердцах зрителей. На нашем ресурсе вы можете смотреть онлайн все видео любимого автора бесплатно и в хорошем качестве. Нам важно, чтобы вы видели каждую деталь и слышали каждый нюанс, поэтому мы используем только стабильные плееры из открытых источников Rutube.
Следите за новинками канала, пересматривайте старые шедевры и открывайте для себя новые грани творчества «Забота о растениях: секреты и рецепты». Мы постоянно обновляем ленту, чтобы у вас под рукой всегда были самые свежие выпуски. Никаких сложных регистраций — только вы и творчество, которое вдохновляет. Приятного вам путешествия по миру авторского контента на RUVIDEO!
Видео взято из открытых источников Rutube. Если вы правообладатель, обратитесь к первоисточнику.